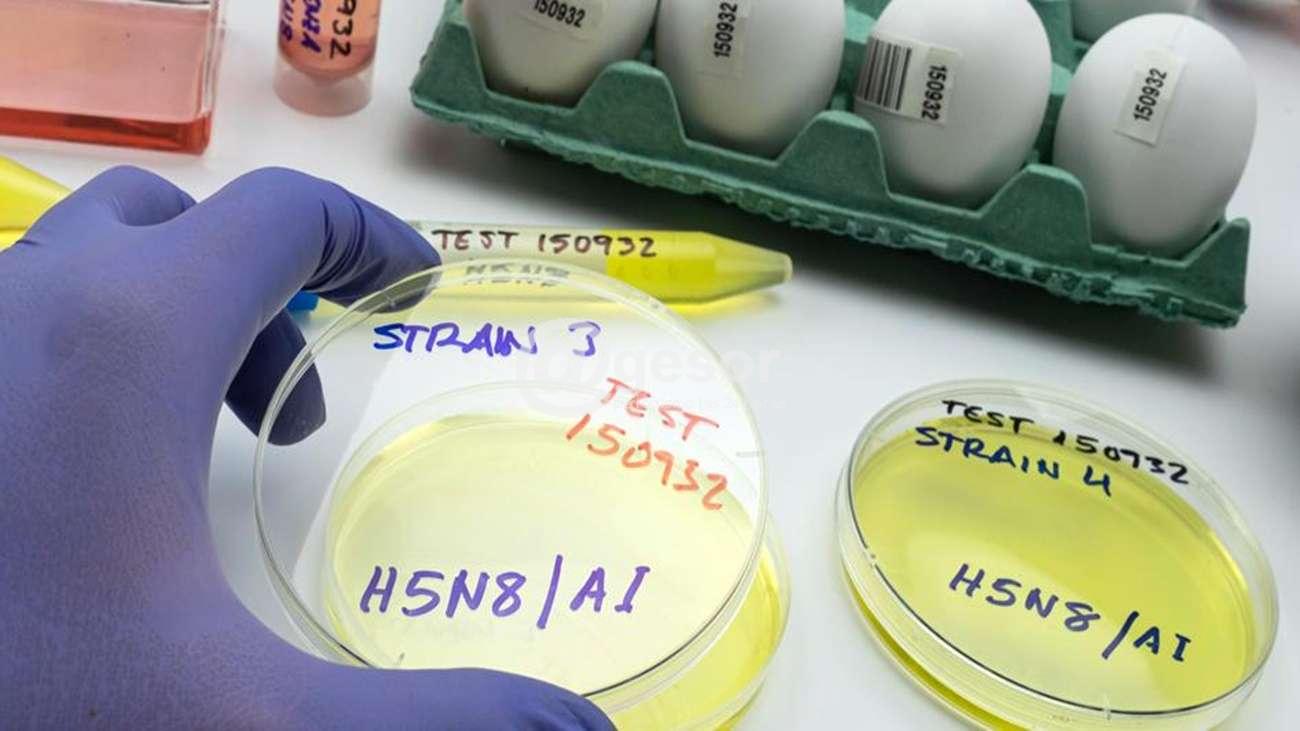

El equipo de @gesor agradece desde ya vuestro aporte, el que nos permitirá seguir creciendo y brindando cada vez más contenido.
| Moneda | Compra | Venta |
![]() |
38.05 | 41.05 |
![]() |
0.05 | 0.35 |
![]() |
7.23 | 9.23 |
![]() |
40.54 | 45.39 |

La Influenza aviar (IA) ha tenido durante el 2022 una rápida propagación en Colombia. Perú y Ecuador, en un contexto de incremento a nivel mundial. Ante esta situación resulta fundamental intensificar los esfuerzos para evitar el ingreso de esta enfermedad que nunca ha sido diagnosticada en Uruguay.
Este virus se clasifica en dos categorías basadas en la severidad de la enfermedad que produce: de baja patogenicidad (signos clínicos leves o imperceptibles) y de alta patogenicidad (cuadros severos llegando a matar el 100% de las aves).
La enfermedad es producida por un virus de alta difusión entre las aves silvestres residentes y migratorias, aves de traspatio y comerciales, lo cual genera grandes pérdidas en la industria avícola.
Las personas que mantienen contacto directo con las aves pueden verse afectadas, pero es importante resaltar que no presenta riesgo para la salud pública el consumo de carne de ave ni de huevos.
Por este motivo el MGAP recomienda al sector avícola:
- Extremar las medidas de bioseguridad en las granjas
- Restricción del ingreso de personas y vehículos al establecimiento
- Estricta limpieza y desinfección de los materiales de trabajo, de las instalaciones y vehículos que ingresan a la granja
- Mantener al día los registros de visitas y productivos
- Malla antipájaro en buen estado en laterales y portones del galpón
- Dispositivos de desinfección a la entrada del establecimiento y de los galpones
- Uso de ropa exclusiva para trabajar con las aves
- Evitar el contacto de las aves comerciales con las silvestres
- Evitar que aves domésticas compartan fuentes de agua con las aves silvestres
Ante esta situación regional el MGAP solicita se le notifique de forma inmediata, cualquier sintomatología compatible con la enfermedad en aves silvestres, de traspatio o comerciales.
Sintomatología:
- Muerte rápida.
- Problemas respiratorios: jadeos, tos, conjuntivitis, secreciones oculares y nasales (mocos), sinusitis, asfixia.
- Signos nerviosos: incoordinación, temblores, movimientos oculares y de cabeza, parálisis, convulsiones.
- Disminución brusca de la postura, o huevos deformes con cáscara blanda o delgada.
- Color azulado o hemorragia de crestas, barbillas y patas.
- Edema en la cabeza (cabeza hinchada).
- Plumaje erizado
- Diarrea
Ante una sospecha:
- No manipular ni mover del lugar las aves afectadas
- Usar equipos de protección personal (lentes, guantes, tapabocas, mamelucos y calzados adecuados)
A los lectores de @gesor que realizan comentarios, en particular a quienes ingresan en la condición de incógnito, no se molesten en hacer comentarios ya no son publicados debido a que no dejan registro de IP ante eventual denuncia de alguna persona que se sienta dañada por ellos.
Igualmente reiteramos lo que hemos escrito en anteriores oportunidades, que pueden referirse con la dureza que se entienda pertinente pero siempre dentro del respeto general y no discriminando ni agraviando, o con expresiones que de alguna manera inciten a la violencia. Los comentarios son una herramienta maravillosa que debemos preservar entre todos.